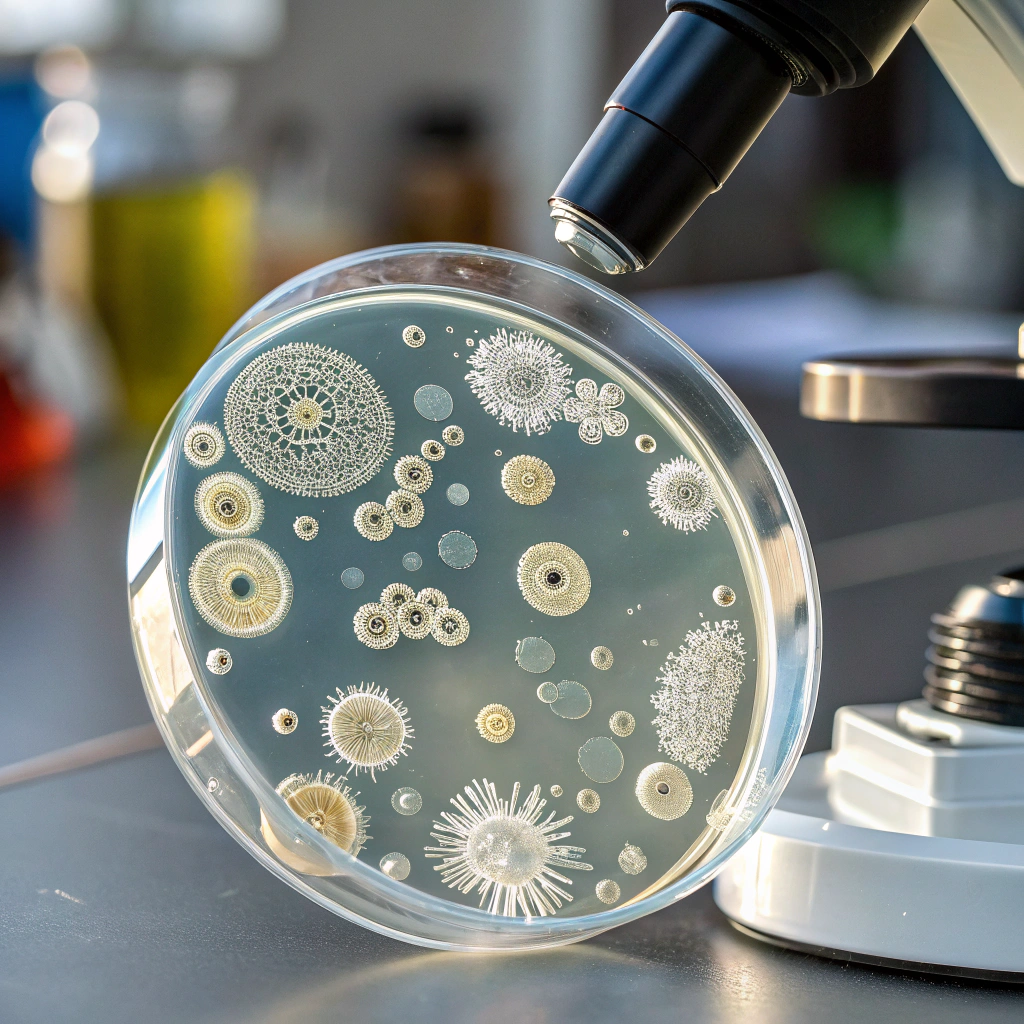

Hospitalización
Cómo interpretar un test SNAP y sus falsos positivos
Los tests SNAP son pruebas rápidas inmunológicas de uso rutinario en la clínica veterinaria. Se utilizan para la detección de…
Fracturas en gatos: estabilización y decisiones urgentes
Las fracturas en gatos son un motivo de consulta, generalmente asociadas a traumatismos por caídas, atropellos o peleas. Se trata…